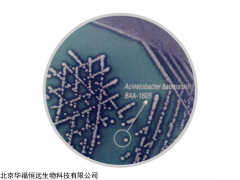
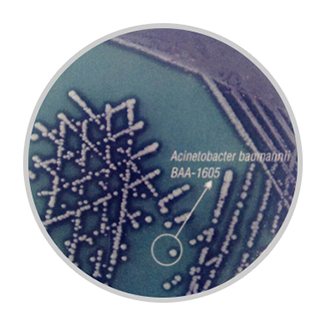

| 提交询价信息 |
| 发布紧急求购 |

价格:电议
所在地:河南 濮阳市
型号:M1938
更新时间:2024-04-16
浏览次数:833
公司地址:北京市朝阳区远洋国际中心
![]()
程艳蕾(女士)
印度HiMedia 不动杆菌显色培养基
品牌:HiMedia
货号:M1938
规格:500G/瓶
用途:从环境和临床样本中选择性分离多重耐药不动杆菌
印度HiMedia 不动杆菌显色培养基 原理
不动杆菌是广泛存在的革兰氏阴性菌,它可从医院感染患者、环境、土壤和水中分离出来。对于每种类型的感染,不动杆菌最为常见。近些年来,鲍曼不动杆菌被人们发现对许多常用的抗生素都耐药,包括β内酰胺类和氨基糖甙类。其中,需要机械通气的免疫力下降患者最具有感染不动杆菌的高风险。
培养基中的特别蛋白胨提供氮源、碳源化合物、氨基酸、维生素和其他必要的生长因子。氯化钠维持渗透压平衡。选择因子抑制革兰氏阳性菌。显色混合剂能将不动杆菌与其他菌相鉴别。
培养基成分
|
组成 |
g/L |
|
特别蛋白胨 |
9 |
|
氯化钠 |
5 |
|
选择因子 |
0.5 |
|
显色混合剂 |
1.35 |
|
琼脂 |
15.00 |
|
最终pH值(25°C) 7.0±0.2 |
|
印度HiMedia 不动杆菌显色培养基 配制
30.85g重悬于1000ml蒸馏水。加热至沸腾使完全溶解。请勿高压灭菌。冷却至45-50°C。无菌加入2管复溶的
MDR选择性添加剂(货号:FD271)或2管利兹不动杆菌选择性添加剂(货号:FD335)。混匀并倾注平板。
质量控制
外观——淡黄色至黄色均匀自由流动粉末
制备好的培养基颜色和透明度——黄色至淡紫色透明至轻微不透明凝胶
培养反应
加添加剂后培养35-37°C 24-48 小时,结果如下:
|
菌种 |
接种量(CFU) |
生长 |
CFU菌落数 |
加FD271后的回收率 |
菌落颜色 |
|
鲍曼不动杆菌ATCC BAA-1605 |
50 -100 |
旺盛 |
25-100 |
≥50% |
淡紫色,有光晕 |
|
鲍曼不动杆菌ATCC BAA-747 |
≥103 |
抑制 |
0 |
0% |
- |
|
鲍曼不动杆菌ATCC 19606 |
≥103 |
抑制 |
0 |
0% |
- |
|
洛菲(鲁氏)不动杆菌ATCC 15309 |
≥103 |
抑制 |
0 |
0% |
- |
|
溶血不动杆菌ATCC 19002 |
≥103 |
抑制 |
0 |
0% |
- |
|
大肠杆菌ATCC 25922(WDCM 00013) |
≥103 |
抑制 |
0 |
0% |
- |
|
粪肠球菌ATCC 29212(WDCM 00087) |
≥103 |
抑制 |
0 |
0% |
- |
注:鲍曼不动杆菌ATCC BAA-1605:对头孢他啶,庆大霉素,替卡西林,哌拉西林,氨曲南,头孢吡肟,环丙沙星,亚胺培南和美罗培南有抗药性。对阿米卡星和妥布霉素敏感。
鲍曼不动杆菌ATCC BAA-747和ATCC 19606均非耐药型。
存储条件
2-8℃
 免责声明:以上所展示的[M1938 印度HiMedia 不动杆菌显色培养基]信息由会员[北京华福恒远生物科技有限公司]自行提供,内容的真实性、准确性和合法性由发布会员负责。
免责声明:以上所展示的[M1938 印度HiMedia 不动杆菌显色培养基]信息由会员[北京华福恒远生物科技有限公司]自行提供,内容的真实性、准确性和合法性由发布会员负责。